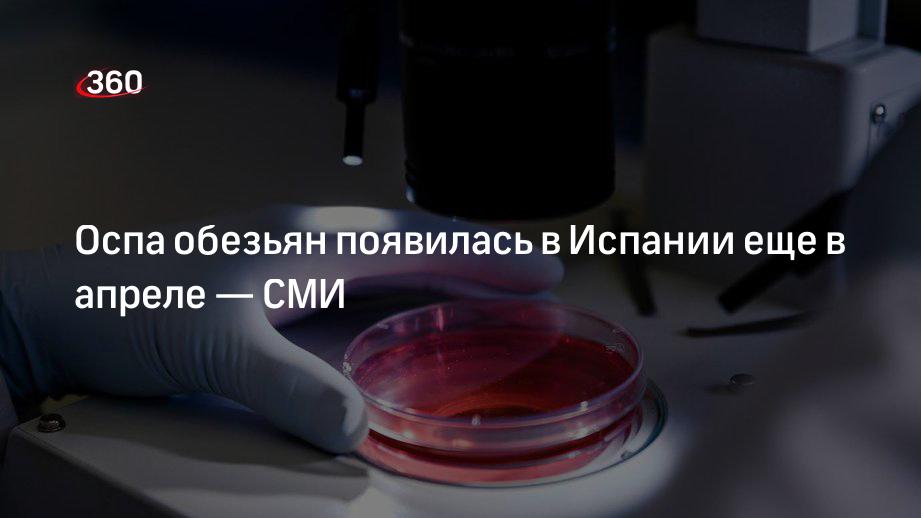

Можно ли вылечиться от оспы обезьян
Уитни хьюстон и иглесиас песня перевод
Сэнсэй sensei
Lady gaga donatella
Что означает карта 10 черви
Dra c
Головоломка головоломок wuthering waves
Зануление в розетке
Фанфики локвуд
Пониженный нейтрофилы у ребенка 2 года
6 июля 2007
Платье сенси
66 890
Керамика для кузова
Можно ли вылечиться от оспы обезьян 105 фото